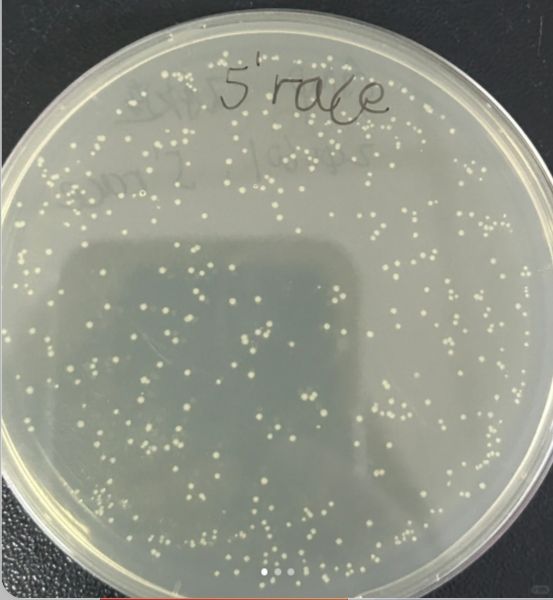

RACE實驗深度探索:從原理到應用的全面解析
2024-12-24 17:25:56
來源/作者:普拉特澤-生物醫學整體課題外包平臺
RACE實驗深度探索總結普拉特澤生物技術為大家總結分享。本文是關于RACE實驗的最后一篇介紹,前面我們學習了RACE實驗提高擴增特異性和效率的新方法、RACE實驗與基因表達分析、探索RACE實驗在疾病相關基因研究中的應用價值,RACE實驗有哪些發展趨勢?可以點擊標題直接傳送回去學習的哦。普拉特澤生物工具檢測平臺承接RACE實驗外包上百例~
早就為大家把實驗過程中要踩的雷、吃的虧幫大家吃完了,現在我們就來看看RACE實驗從原理到應用的全面解析RACE,即cDNA末端快速擴增技術(rapid amplification of cDNA ends),是一種基于逆轉錄PCR從樣本中快速擴增cDNA的5′端及3′端的技術。
該技術由Frohman等人于1988年發明,為分子生物學研究提供了強有力的工具。
以下是對RACE實驗從原理到應用的全面解析
前期回顧:

——RACE技術的原理
RACE技術的核心在于利用已知的部分cDNA序列,通過逆轉錄和PCR擴增,獲得完整的cDNA的5′和3′端序列。這一過程分為3′RACE和5′RACE兩部分。
?3′RACE?:
實驗樣本通常為總RNA或poly(A)+RNA。
首先根據mRNA 3′末端天然存在的Poly(A)尾部設計反轉錄引物,逆轉錄獲得第一條cDNA鏈。
根據已知的cDNA序列設計基因特異性引物(GSP),合成第二條cDNA鏈。
隨后以GSP及正義鏈3′末端引物作為一對引物,對得到的cDNA鏈進行PCR擴增,從而得到cDNA的3′端序列。
?5′RACE?:
同樣以總RNA或poly(A)+RNA為實驗樣本。
根據已知的cDNA序列設計GSP,逆轉錄獲得第一條cDNA鏈。
同時用末端脫氧核苷酸轉移酶(TdT)在cDNA 3′端加Poly(C)尾。
依據Poly(C)尾設計特定引物合成第二條cDNA鏈。
隨后以第二條cDNA鏈為模板利用GSP合成雙鏈cDNA。
最后以GSP及反義鏈3′末端引物為一對引物進行PCR擴增,獲得cDNA 5′端序列。


——RACE技術的類型及特點
隨著分子生物學技術的發展,RACE技術也經歷了多次改進,形成了多種類型,包括經典RACE、Adapter-Ligated RACE、RLM-RACE、Cap-switching RACE和環形RACE等。
?經典RACE?:適用于擴增有poly(A)尾結構的RNA。
?Adapter-Ligated RACE?:利用T4連接酶將接頭與cDNA兩末端連接,使長片段cDNA的克隆在擴增反應中占主導。
?RLM-RACE?:針對mRNA斷裂的可能進行了技術優化,通過切除斷裂mRNA 5′端暴露的磷酸基團并連接接頭,實現完整mRNA 5′末端的擴增。
?Cap-switching RACE?:適用于擴增具有5′端帽子結構的RNA,通過逆轉錄酶在cDNA 3′端加上胞嘧啶殘基并引入接頭序列,實現5′端序列的擴增。
?環形RACE?:利用T4連接酶將cDNA的末端連接形成環化結構或串聯結構,通過設計特異性引物進行PCR擴增
RACE實驗在生物學研究中扮演著舉足輕重的角色,其應用廣泛且深入。除了之前提到的克隆全長cDNA、構建cDNA文庫以及克隆已知片段的旁側內部序列外,RACE實驗還在以下領域發揮著重要作用:
?克隆同源基因的同源片段?:
在進化生物學和比較基因組學的研究中,RACE實驗能夠幫助我們克隆同源基因的同源片段。通過比較不同物種中同源基因的序列差異,我們可以深入了解基因的進化歷程和功能變化。
?獲得抗體可變區序列?:
在抗體工程中,RACE實驗是一種重要的技術手段。通過RACE實驗,我們可以從B細胞中擴增出抗體基因的可變區序列,進而設計并優化抗體,以滿足特定的診斷和治療需求。
?miRNA靶基因序列驗證?:
miRNAs作為一類重要的調控分子,在基因表達調控中發揮著關鍵作用。RACE實驗可以用于驗證miRNA的靶基因序列,從而揭示miRNA在基因調控網絡中的具體作用機制。
?基因表達調控研究?:
RACE實驗還可以用于研究基因表達的調控機制。通過比較不同條件下基因5′端和3′端序列的變化,我們可以了解啟動子、增強子以及轉錄后調控元件對基因表達的影響。
——疾病相關基因的發現與研究?:
在疾病研究中,RACE實驗有助于我們發現與疾病相關的基因。通過擴增并克隆疾病相關基因的cDNA全長序列,我們可以進一步探索其在疾病發生和發展中的作用機制,為疾病的診斷和治療提供新的思路和方法。
綜上所述,RACE實驗作為一種強大的分子生物學工具,在生物學研究中具有廣泛的應用前景。通過不斷的技術改進和創新,RACE實驗將在更多領域發揮重要作用,推動生物學研究的深入發展。

今天關于RACE實驗從原理到應用的全面解析就分享到這兒啦~如果您在實驗過程中遇到技術問題,或者需要實驗外包和代做,可與我們技術老師聯系18570028002(微信同號)
